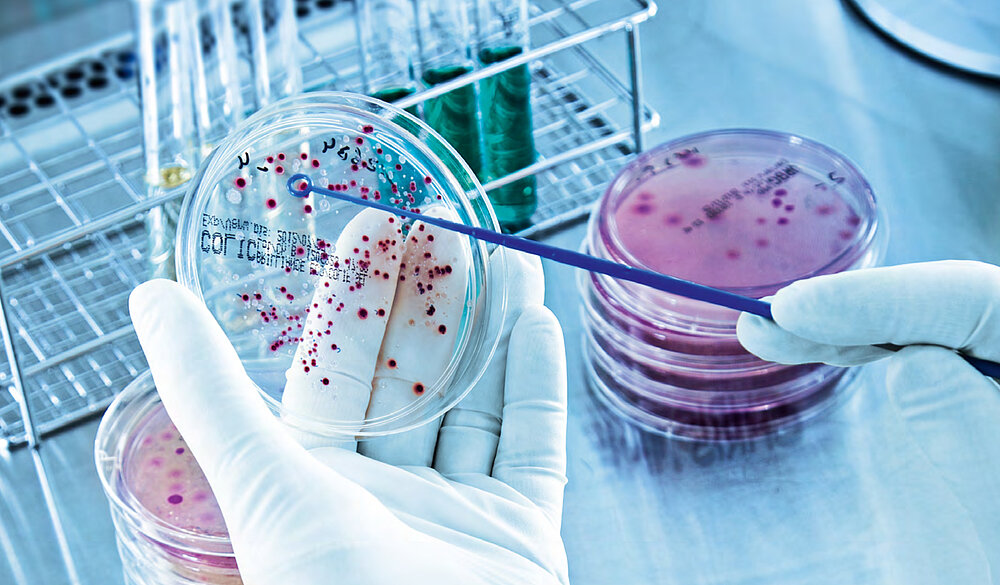

Das Flush-Brush-Flush Verfahren zur Überprüfung aufbereiteter Endoskope

Das Flush-Brush-Flush-Verfahren (FBF) rückt zunehmend in den Fokus der Diskussion zur hygienisch mikrobiologischen Überprüfung aufbereiteter flexibler Endoskope. Eine aktuelle Publikation von Wehrl et al. stellt die Methode ausführlich vor und beschreibt den wissenschaftlich technischen Hintergrund sowie die praktischen Schritte. Die Autorengruppe zeigt, wie Spülung, Bürstung und erneute Spülung methodisch einzuordnen sind und welche Ergebnisse die Feldstudie ergab. Die zuverlässige Beurteilung der hygienisch- mikrobiologischen Qualität aufbereiteter flexibler Endoskope erfordert Verfahren, die eine mikrobielle Kontamination möglichst vollständig erfassen. Derzeit erfolgt die hygienisch-mikrobiologische Überprüfung über Abstrich- und Durchspülproben. Entscheidend ist dabei die Wiederfindungsrate, also der Anteil der tatsächlich im Kanal vorhandenen Mikroorganismen, der nachgewiesen werden kann. Niedrige Wiederfindungsraten unterschätzen die mikrobielle Belastung und können dazu führen, dass relevante Erreger unentdeckt bleiben.
Während in Deutschland überwiegend reine Spülverfahren eingesetzt werden, nutzen Länder wie Frankreich bereits mechanisch unterstützte Methoden wie das FBF-Verfahren, bei dem der Endoskopkanal gespült, gebürstet und anschließend erneut gespült wird, um mehr Mikroorganismen zuverlässig zu lösen und nachzuweisen. Auch in Studien zur mikrobiellen Gesamtbelastung (Bioburden) klinisch genutzter Endoskope wurde das FBF-Verfahren bereits herangezogen. Ebenso kamen zur Abklärung von Ausbruchsituationen Methoden mit mechanischer Komponente zur Anwendung. Nach vermehrten Berichten über Übertragungen multiresistenter Erreger durch Duodenoskope empfahl die FDA 2015 regelmäßige mikrobiologische Kontrollen. Rein spülbasierte Verfahren konnten kritische Keime oft nicht nachweisen, während FBF bei zwei Dritteln der Duodenoskope pathogene Mikroorganismen fand. Methodische Vergleichsuntersuchungen der Methodengruppe 2.0 zeigten, dass die Zusammensetzung des Elutionsmittels im Prüfkörpermodell keinen signifikanten Einfluss auf die Wiederfindungsrate hat. Bei reinen Durchspülverfahren unter Verwendung standardisierter Prüfkörper liegen die Wiederfindungsraten typischerweise nur bei 0,1 – 2 %. Aufgrund der geringen Wiederfindungsraten reiner Durchspülverfahren wurde 2018 die Methodengruppe 2.0 mit der Entwicklung optimierter Elutionsverfahren beauftragt, koordiniert von PD Dr. Holger Biering, Dr. Birgit Kampf und Dr. Markus Wehrl.
Die Methodenentwicklung erfolgte in einem abgestuften Verfahren. Zunächst wurden systematische Untersuchungen der Wiederfindungsraten verschiedener Elutionsverfahren mit standardisierten Prüfkörpern durchgeführt. Insgesamt führten die zwölf Labore der Methodengruppe 2.0 sechs Vergleichsstudien zur Entwicklung und Charakterisierung des neuen FBF-Verfahrens durch. Anschließend wurde das Verfahren in einer Pilotstudie an sechs Endoskopkanal Typen mit unbekanntem mikrobiologischem Status überprüft. In einer abschließenden Feldstudie kam das FBF-Verfahren zur Beprobung der Instrumentierkanäle von 101 aufbereiteten Endoskopen nach Patientenanwendung und anschließender Aufbereitung zum Einsatz.
Für die Untersuchungen in den Laboren der Methodengruppe 2.0 standen standardisierte Materialien und Geräte zur Verfügung. Dazu gehörten grundlegende Verbrauchsmaterialien, Handdesinfektionsmittel, sterile 50 ml Spritzen mit Luer- Anschluss sowie sterile Auffanggefäße. Für die Bürstenschritte wurden neue, einzeln verpackte Endoskop-Reinigungsbürsten und sterile Scheren oder Seitenschneider bereitgestellt. Zur weiteren Probenverarbeitung kamen sterile Glasperlen, ein Horizontalschüttler, Schafblutagarplatten sowie eine Membranfiltrationsapparatur mit passenden Filtern zum Einsatz.
Je nach zuvor verwendeter Desinfektionschemikalie wurden zwei unterschiedliche Elutionsmittel (NaCl-TG oder NaCl-TLH Thio) verwendet, die jeweils auf pH 7 eingestellt und anschließend autoklaviert wurden.
Vor der Beprobung wurden Endoskoptyp, Gerätenummer, Art der Aufbereitung, eingesetzte Reinigungs- und Desinfektionschemikalien sowie die Zeit zwischen Aufbereitung und Beprobung dokumentiert. Auch die verwendeten Endoskop-Reinigungsbürsten wurden erfasst. Das Elutionsmittel wurde entsprechend dem eingesetzten Desinfektionswirkstoff ausgewählt. Die Probennahme erfolgte aseptisch, um Kontaminationen zu vermeiden. Je nach Bauart wurde das Endoskop aufgehängt oder auf einer keimfreien Unterlage gelagert, um eine kontaktfreie Probenentnahme sicherzustellen.
Unter Verwendung einer sterilen Spritze mit 50 ml des ausgewählten Elutionsmittels wurden 25 ml in den Anschluss des Instrumentierkanals injiziert (1. Flush). Der Anschluss erfolgte bevorzugt flüssigkeitsdicht über den Luer-Anschluss, sofern vorhanden; andernfalls wurde das Elutionsmittel vorsichtig ohne Verspritzen in den Kanal gegeben. Das am Distalende austretende Eluat wurde in einem sterilen Auffanggefäß aufgefangen, dessen Wand zur Vermeidung von Kontaminationen nicht berührt werden durfte. Anschließend wurden durch Injektion von 2 × 50 ml Luft Rückstände ausgeblasen; bei fehlendem Luer-Anschluss entfiel dieser Schritt. Das Volumen des aufgefangenen Eluats des 1. Flush wurde dokumentiert.
Danach wurde der Bürstenkopf einer passend ausgewählten Endoskop-Reinigungsbürste mit dem jeweiligen Elutionsmittel angefeuchtet, in den Anschluss des Instrumentierkanals eingeführt und zum Distalende vorgeschoben (Brush). Der am Distalende des Endoskops austretende Bürstenkopf wurde zusammen mit ca. 1 cm Bürstenschaft mittels steriler Schere oder sterilem Seitenschneider abgetrennt und in einem zweiten, neuen, sterilen Auffanggefäß aufgefangen. Der im Kanal verbliebene Bürstenschaft wurde vorsichtig rückwärts herausgezogen und verworfen. Der abgetrennte und aufgefangene Bürstenkopf wurde im Auffanggefäß visuell auf mögliche Rückstände überprüft. Anschließend erfolgte das zweite Durchspülen (2. Flush) durch Injektion der restlichen 25 ml Elutionsmittel; die Vorgehensweise entsprach dem 1. Flush. Das Eluat wurde im zweiten, bereits den Bürstenkopf enthaltenden Auffanggefäß, gesammelt. Durch Injektion von 2 × 50 ml Luft wurden Rückstände ausgeblasen. Das Volumen des aufgefangenen Eluats aus Brush und 2. Flush wurde dokumentiert. Nach der Probennahme wurden die Proben schnellstmöglich ins Labor transportiert, sodass eine Weiterverarbeitung innerhalb von 24 h gewährleistet war. Bei Transportzeiten von mehr als 4 h erfolgte der Transport gekühlt (< 6 °C).
In jedes Auffanggefäß wurden 10 g sterile Glasperlen (Durchmesser 3 mm) zugegeben. Das Eluat wurde 30 min auf einem Horizontalschüttler bei 300 rpm (bei dokumentierter Raumtemperatur) homogenisiert. Das Gesamtvolumen des homogenisierten Eluats wurde membranfiltriert (Membranfilterdurchmesser 47 mm, Membranporengröße 0,2 μm). Die Filtermembran wurde aseptisch auf eine Schafblutagarplatte transferiert und bei 36 ± 1 °C aerob inkubiert. Die erste Ablesung und Dokumentation der Gesamtkoloniezahl erfolgte nach 24 ± 2 h, die zweite Ablesung nach 48 ± 4 h.
In der Feldstudie wurde das Flush-Brush- Flush-Verfahren in 34 Einrichtungen angewendet, dabei wurden 101 Endoskope untersucht. Die untersuchten Typen umfassten Koloskope, Gastroskope, Duodenoskope und Bronchoskope verschiedener Hersteller. Die Aufbereitung erfolgte maschinell oder manuell unter Einsatz von Glutaraldehyd oder Peressigsäure. Die Ergebnisse wurden anonymisiert ausgewertet.
Für die n = 101 untersuchten Endoskope wurden folgende Ergebnisse für die Gesamtkoloniezahl der Eluate des 1. Flush bestimmt: n = 60 Endoskope (59 % von n = 101 Endoskopen) wiesen keine nachweisbaren Mikroorganismen auf, n = 35 Endoskope (35 % von n = 101 Endoskopen) wiesen Zellzahlen von 1 – 20 KBE (Koloniebildende Einheiten) auf und n = 6 Endoskope (6 % von n = 101 Endoskopen) wiesen Zellzahlen von > 20 KBE auf, s. Abb. 1.
Für die n = 101 untersuchten Endoskope wurden folgende Ergebnisse für die Gesamtkoloniezahl der eluierten Bürstenköpfe (Brush) zusammen mit den Eluaten des 2. Flush bestimmt: n = 36 Endoskope (36 % von n = 101 Endoskopen) wiesen keine nachweisbaren Mikroorganismen auf, n = 49 Endoskope (48 % von n = 101 Endoskopen) wiesen Zellzahlen von 1 – 20 KBE auf und n = 16 Endoskope (16 % von n = 101 Endoskopen) wiesen Zellzahlen von > 20 KBE auf, s. Abb. 2.
einfachen Durchspülen (1. Flush). Während beim 1. Flush noch 59 % der Endoskope keine Mikroorganismen aufwiesen, sank dieser Anteil nach Brush und 2. Flush auf 36 %. Die Kombination aller Schritte reduzierte ihn weiter auf 26 %. Für die Kategorie > 20 KBE stieg der prozentuale Anteil der Endoskope von 6 % für 1. Flush auf 16 % für Brush und 2. Flush bzw. 22 % der Instrumente für die Addition von 1. Flush, Brush und 2. Flush.

Abb. 1: Prozentuale Verteilung der durch den 1. Flush des Instrumentierkanals ermittelten Gesamtkoloniezahlen, eingeteilt in 0 KBE, 1 – 20 KBE und > 20 KBE je Instrumentierkanal. Abb. 2: Prozentuale Verteilung der durch Elution der Bürstenköpfe (Brush) und 2. Flush des Instrumentierkanals ermittelten Gesamtkoloniezahlen, eingeteilt in 0 KBE, 1 – 20 KBE und > 20 KBE je Instrumentierkanal.
Durch die Addition der Gesamtkoloniezahlen der Eluate des 1. Flush und der eluierten Bürstenköpfe und der Eluate des 2. Flush (die Addition erfolgte für jedes Endoskop separat) – was der Sammlung beider Durchspülproben und der Bürstenköpfe in einem Auffanggefäß entsprechen würde – ergaben sich folgende Ergebnisse: n = 26 Endoskope (26 % von n = 101 Endoskopen) wiesen keine nachweisbaren Mikroorganismen auf, n = 53 Endoskope (52 % von n = 101 Endoskopen) wiesen Zellzahlen von 1 – 20 KBE auf und n = 22 Endoskope (22 % von n = 101 Endoskopen) wiesen Zellzahlen von > 20 KBE auf.
Durch den Einsatz einer Endoskop-Reinigungsbürste mit anschließendem zweiten Spülschritt (Brush, 2. Flush) wurden bei mehr Instrumenten Mikroorganismen nachgewiesen als beim Die Ergebnisse zeigen, dass die Wiederfindung von Mikroorganismen durch den Einsatz einer Endoskop-Reinigungsbürste, gefolgt von einem zweiten Spülschritt, deutlich verbessert werden kann. Dadurch sinkt das Risiko falsch negativer Befunde, und unzureichend aufbereitete Endoskope werden zuverlässiger erkannt – ein wichtiger Beitrag zur Sicherheit von Patienten und Anwendern. Das bislang auf einfachem Durchspülen basierende Verfahren zur Beprobung der Kanäle sollte daher durch das FBF-Verfahren ersetzt werden.
Dr. Markus Wehrl et al.,
wfk – Cleaning Technology
Institute e.V.; Krefeld